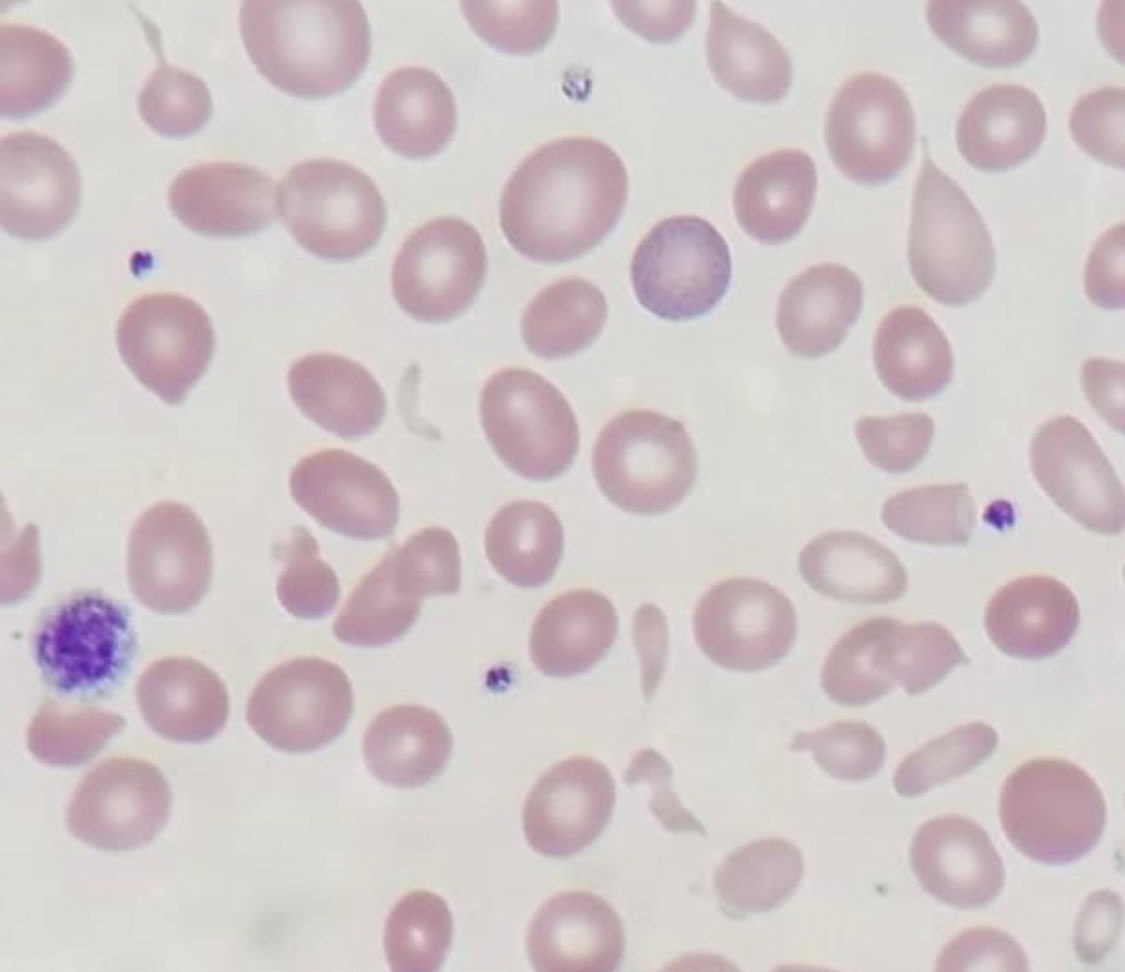

اذا لا يوجد اختلافات كبيره بين الاحجام و بالتالي راح يكون (RDW) طبيعي بمعني لا يوجد (variation) بين احجام كرات الدم الحمراء
اما لو ان بعض كريات الدم الحمراء في نطاق الحجم الطبيعي و اخرى احجامها اصغر او اكبر بشكل ملحوظ فهذا يدل ان هناك (variation) بين احجام كرات الدم الحمراء
اما لو ان بعض كريات الدم الحمراء في نطاق الحجم الطبيعي و اخرى احجامها اصغر او اكبر بشكل ملحوظ فهذا يدل ان هناك (variation) بين احجام كرات الدم الحمراء
و بالتالي يرتفع ال (RDW) طيب كيف يتم حساب ال (RDW)🤔⁉️
يوجد لدي نوعين للحساب
(RDW-SD) او (RDW- Standard deviation) و هذه قيمه بتقيس عندي مباشره من على هيستوجرام كرات الدم الحمراء (عند 20% من كرات الدم)
و هذا يدل على ان الجهاز بيشوف اصغر حجم تم قياسه ل 20% من كريات الدم الموجوده
يوجد لدي نوعين للحساب
(RDW-SD) او (RDW- Standard deviation) و هذه قيمه بتقيس عندي مباشره من على هيستوجرام كرات الدم الحمراء (عند 20% من كرات الدم)
و هذا يدل على ان الجهاز بيشوف اصغر حجم تم قياسه ل 20% من كريات الدم الموجوده
و بيشوف اكبر حجم تم قياسه ل 20% من كرات الدم الموجوده و ببساطه يحسب الفرق بينهم و ده بيكون القيمه (RDW-SD) و الرنج الطبيعي له (39-46 fL) و منطقيا طبعا كلما كان في (variation) فى الاحجام كل ما كان المنحني اوسع و بالتالي قيمه ال (RDW-SD) اكبر
او (RDW-CV)
او (RDW-CV)
(RDW- Coefficient of Variation) وهذه نسبه مئويه تحسب بقسمه (1 SD of RBC volume) على (MCV) ثم الضرب في 100 للحصول على نسبه مئويه و الرنج الطبيعي له (11-15 %)
ملحوظه💡
(1 SD of RBC volume) او ما يعرف بال (Standard deviation of MCV) هذه المسافه تحت الكيرف على ارتفاع (68.2%) من قاعدته يعني عند الحجم اللي يمثله 68% من الخلايا الحمراء
و منطقيا ايضا كلما زادت المسافه تحت الكيرف نتيجه تباين احجام الخلايا كلما ارتفعت قيمه (RDW-CV)
(1 SD of RBC volume) او ما يعرف بال (Standard deviation of MCV) هذه المسافه تحت الكيرف على ارتفاع (68.2%) من قاعدته يعني عند الحجم اللي يمثله 68% من الخلايا الحمراء
و منطقيا ايضا كلما زادت المسافه تحت الكيرف نتيجه تباين احجام الخلايا كلما ارتفعت قيمه (RDW-CV)
بكل بساطه قيمه ال RDW-CVهي نسبه مئويه للانحراف المعياري لاحجام كرات الدم الحمراء عن الحجم المتوسط MCV
و هذه الاكثر شهره فى الاستخدام
طيب السؤال هنا ليش مانقدر
نحسبها مانوال🤔⁉️
ببساطه لان هذه قيمه احصائيه تتطلب وجود عدد كبير من احجام كرات الدم الحمراء وهذا مايقوم بعمله الجهاز
و هذه الاكثر شهره فى الاستخدام
طيب السؤال هنا ليش مانقدر
نحسبها مانوال🤔⁉️
ببساطه لان هذه قيمه احصائيه تتطلب وجود عدد كبير من احجام كرات الدم الحمراء وهذا مايقوم بعمله الجهاز
يقيس حجم كل كرات الدم الحمراء و بالتالي عنده العديد من القيم اللي يقدر يحسب بيها البارمتير(RDW)بينما في المانيوال احنا بنحسب متوسط احجام كل كرات الدم الحمراء كقيمه واحده و هيMCV
طيب هل لو انا بشتغل مانوال🤔اقدر اعطي الدكتور الا بيشخص الحالة انطباع ان فيvariationفى احجام الخلايا⁉️
طيب هل لو انا بشتغل مانوال🤔اقدر اعطي الدكتور الا بيشخص الحالة انطباع ان فيvariationفى احجام الخلايا⁉️
بالتاكيد اقدر وهذا بيتم خلال فحص فيلم الدم معروف ان حجم كره الدم الحمراء الطبيعي يساوي حجم نواه لمفوسيت صغيره و بالتالي طالما عرفت الحجم الطبيعي اقدر بالفحص اشوف هل فى خلايا اكبر فى الحجم او خلايا اصغر فى الحجم مع الخلايا الطبيعيه
و لو فعلا موجوده اكتب تعليق على الحاله
و لو فعلا موجوده اكتب تعليق على الحاله
(RBCs anisopoikilocytosis)
و وهذا معناته ان في (variation) فى احجام و اشكال كرات الدم بمعنى آخر كأني بقول ان (RDW) عالي
طيب ايش الفائدة من (RDW) او كيف بيشتغل؟
(RDW) تستخدم للحكم الاولي او المبدئي على نوع الانيميا الموجوده
فمثلا الحالات(microcytic) و المصاحب لها (RDW) مرتفع
و وهذا معناته ان في (variation) فى احجام و اشكال كرات الدم بمعنى آخر كأني بقول ان (RDW) عالي
طيب ايش الفائدة من (RDW) او كيف بيشتغل؟
(RDW) تستخدم للحكم الاولي او المبدئي على نوع الانيميا الموجوده
فمثلا الحالات(microcytic) و المصاحب لها (RDW) مرتفع
ترجح ان الحاله (iron deficancy anemia) حيث ان نقص الحديد يحدث على مراحل و بالتالي حنلاحظ وجود خلايا صغيره الحجم مصنعه اثناء نقص الحديد بينما يوجد خلايا اخرى اقدم منها طبيعيه الحجم مصنعه وقت ما كان مستوى الحديد مناسب و لذلك فهناك (variation) ادى الى ارتفاع (RDW)
على العكس فى حالات (thalassemia) يوجد فيها ايضا (microcytosis) لكن احجام كل الخلايا صغيره و متساويه الحجم تقريبا (لان المشكله هنا جينيه فالتصنيع من البدايه واحد) و بالتالي لا يوجد (variation) و (RDW) بتكون طبيعيه
في النهاية شكرا د /خالد مجدي على توضيح هذه المعلومة ☺️🙏🏻
في النهاية شكرا د /خالد مجدي على توضيح هذه المعلومة ☺️🙏🏻
جاري تحميل الاقتراحات...